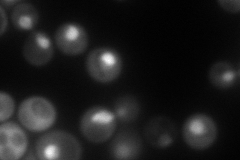
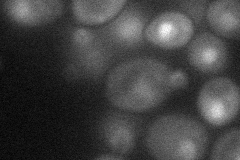
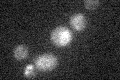

View description
Essential protein involved in transcription regulation; component of chromatin remodeling complexes; required for assembly and function of the INO80 complex; also referred to as reptin; member of the RUVB-like protein family
Localization:
Intensity:
Fold change:
Significance:
-
C’ GFP library in SD

below threshold15.96 -
N' NOP1pr-GFP in SD
nucleus184.841 -
N' TEF2pr-mCherry in SD

cytosol,nucleus136.801 -
N' NATIVEpr-GFP in SD

nucleus89.5818 -
N' TEF2pr-VC and Cyto-VN in SD
cytosol,nucleus38.4328 -
C’ GFP library in SD+DTT

cytosol17.441.09No -
C’ GFP library in SD+H2O2

cytosol16.451.03No -
C’ GFP library in Starvation Media
cytosol14.730.92No -
C’ GFP library on the background of Pup2-DaMP

below threshold -
C’ GFP library on the background of CCT mutant

below threshold18.90081.18379No
